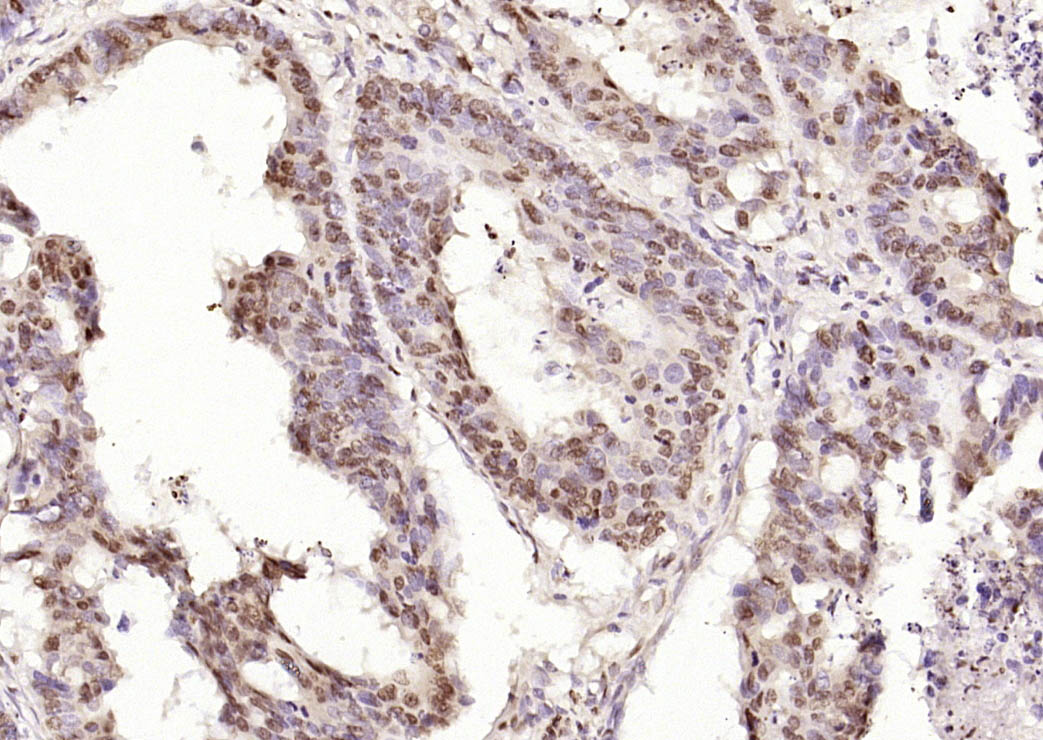
细胞死亡活化蛋白抗体-bs-6796R
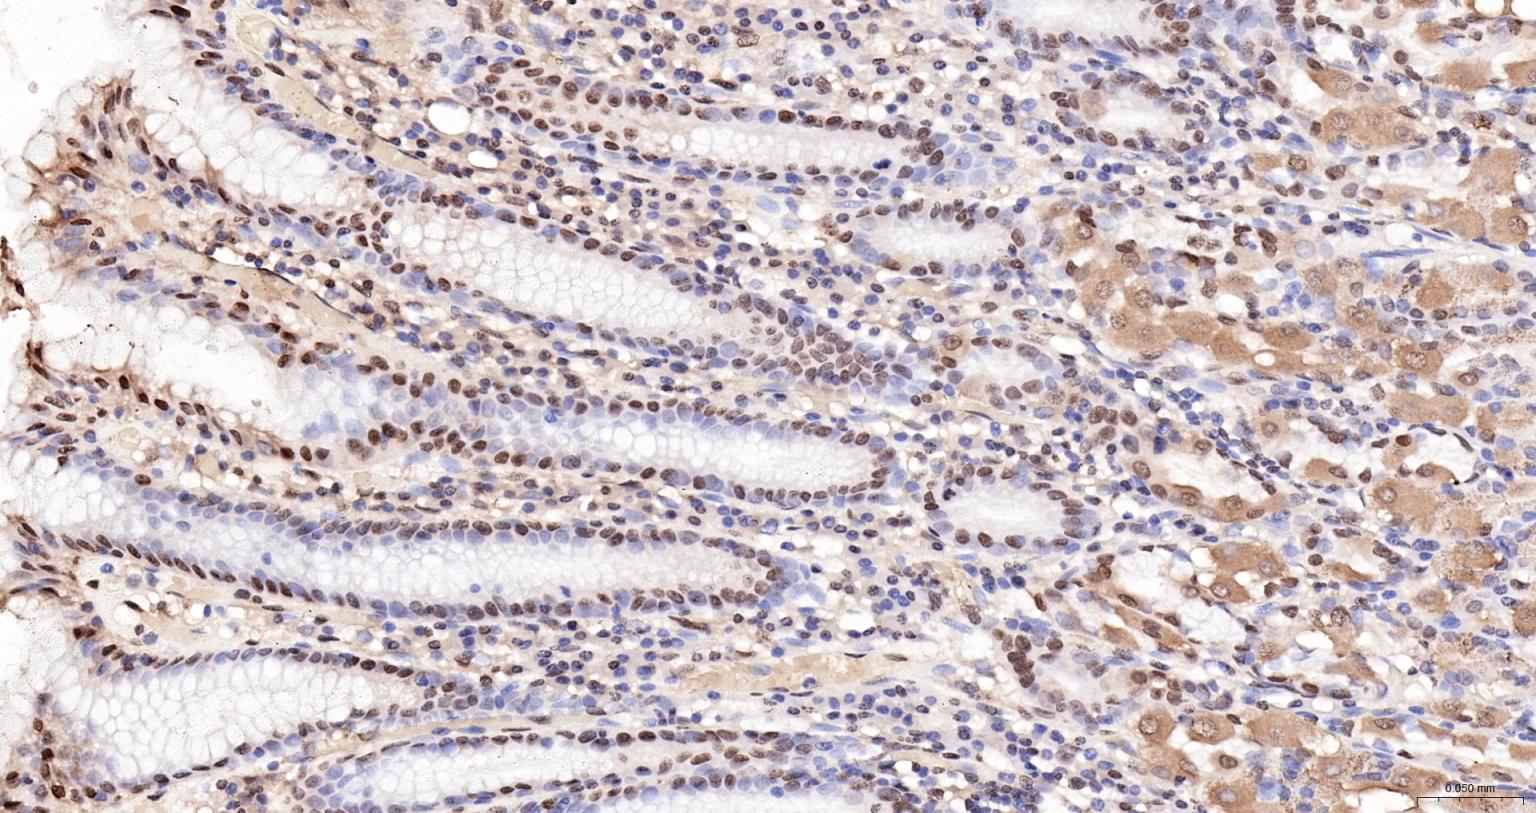
细胞死亡活化蛋白抗体-bs-6796R
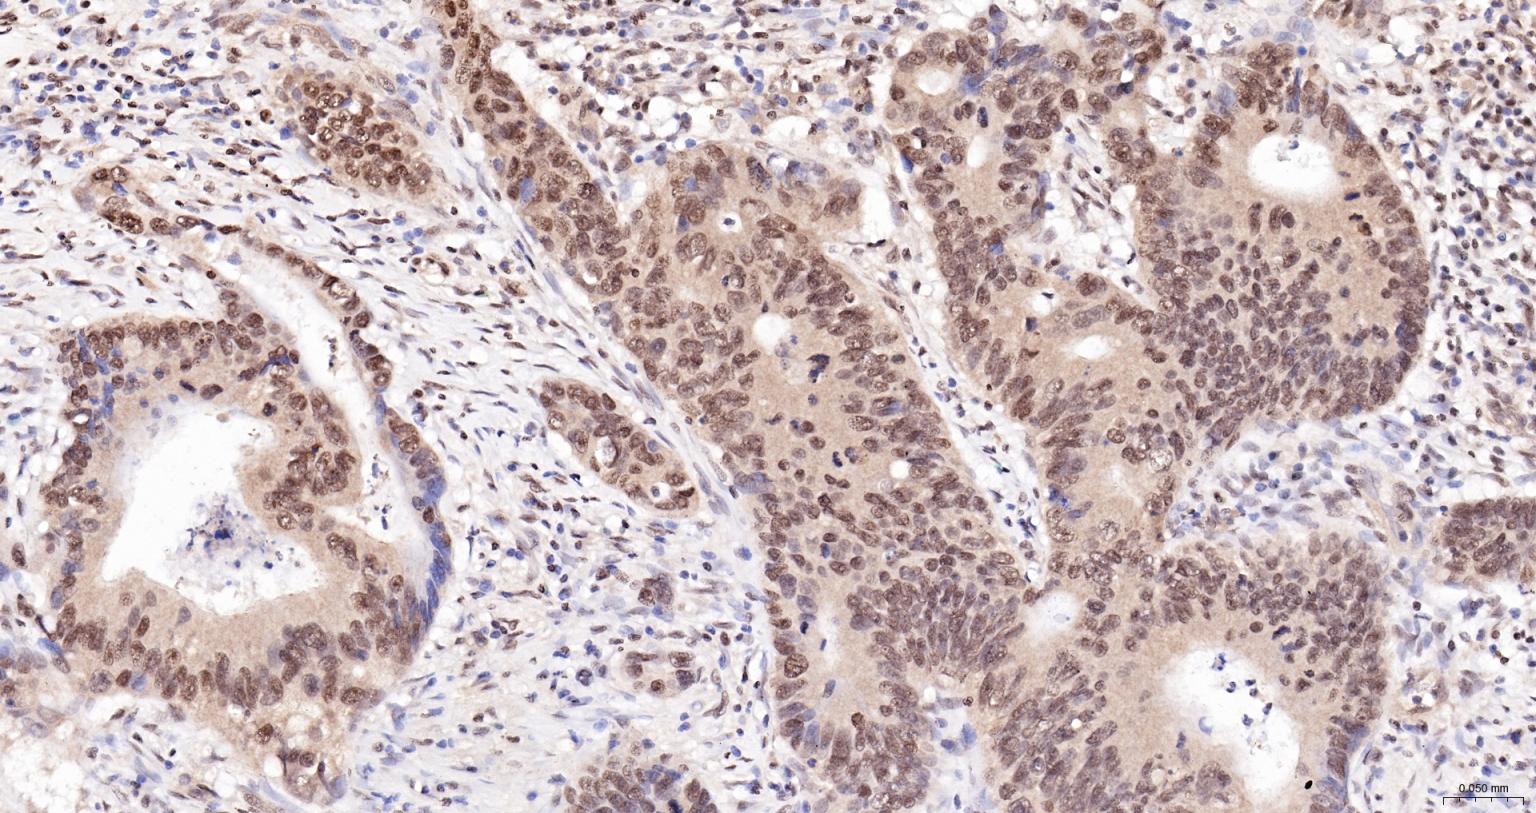
细胞死亡活化蛋白抗体-bs-6796R

CIDEC Rabbit pAb (一抗) - WB,IHC-P,IHC-F,IF,Flow-Cyt,ICC/IF | Bioss

货号:bs-6796R
产品详情
相关标记
相关产品
相关文献
常见问题
概述
产品编号
bs-6796R
产品类型
农牧业/家禽抗体
英文名称
CIDEC Rabbit pAb
中文名称
细胞死亡活化蛋白抗体
英文别名
CIDE-3; CIDE3; FPLD5; FSP27; CIDEC_HUMAN; CIDEC; Cell death activator CIDE-3; Cell death-inducing DFFA-like effector protein C; Fat-specific protein FSP27 homolog; CIDEC_MOUSE; Fat-specific protein FSP27; CIDEC_RAT;
抗体来源
Rabbit
免疫原
KLH conjugated synthetic peptide derived from human CIDEC: 101-200/238
亚型
IgG
性状
Liquid
纯化方法
affinity purified by Protein A
克隆类型
Polyclonal
理论分子量
27 kDa
检测分子量
27 kDa
浓度
1mg/ml
储存液
0.01M TBS (pH7.4) with 1% BSA, 0.02% Proclin300 and 50% Glycerol.
SWISS
Gene ID
保存条件
Shipped at 4℃. Store at -20℃ for one year. Avoid repeated freeze/thaw cycles.
注意事项
This product as supplied is intended for research use only, not for use in human, therapeutic or diagnostic applications.
数据库链接
背景资料
This gene encodes a member of the cell death-inducing DNA fragmentation factor-like effector family. Members of this family play important roles in apoptosis. The encoded protein promotes lipid droplet formation in adipocytes and may mediate adipocyte apoptosis. This gene is regulated by insulin and its expression is positively correlated with insulin sensitivity. Mutations in this gene may contribute to insulin resistant diabetes. A pseudogene of this gene is located on the short arm of chromosome 3. Alternatively spliced transcript variants that encode different isoforms have been observed for this gene. [provided by RefSeq, Dec 2010].
Tissue specificity: Expressed mainly in small intestine, heart, colon and stomach and, at lower levels, in brain, kidney and liver.
Tissue specificity: Expressed mainly in small intestine, heart, colon and stomach and, at lower levels, in brain, kidney and liver.

产品应用
| 应用 | 已检合格种属 | 预测种属 | 推荐稀释比例 |
|---|---|---|---|
| WB | Mouse, Rat | Human, Pig | 1:500-2000 |
| IHC-P | Human, Mouse, Rat | Pig | 1:100-500 |
| IHC-F | Human, Mouse, Rat | Pig | 1:100-500 |
| IF | Human, Mouse, Rat | Pig | 1:100-500 |
| Flow-Cyt | Human, Mouse | Rat, Pig | 1ug/Test |
| ICC/IF | Human, Mouse, Rat, Pig | 1:50-200 |
交叉反应
交叉反应: Human, Mouse, Rat (predicted: Pig)
相关产品
暂无相关产品
靶标
基因名
CIDEC
蛋白名
Cell death activator CIDE-3
亚基
Interacts with CEBPB (By similarity). Interacts withCIDEA.
亚细胞定位
Nucleus (By similarity). Endoplasmicreticulum (By similarity). Lipid droplet. Note=Diffuses quickly onlipid droplet surface, but becomes trapped and clustered at lipiddroplet contact sites, thereby enabling its rapid enrichment atlipid droplet contact sites.
组织特异性
Expressed mainly in adipose tissue, smallintestine, heart, colon and stomach and, at lower levels, in brain,kidney and liver.
翻译后修饰
Ubiquitinated and targeted to proteasomal degradation,resulting in a short half-life. Protein stability depends ontriaclyglycerol synthesis, fatty acid availability and lipiddroplet formation (By similarity).
疾病
Note=In omental adipose tissue of obese patients matchedfor BMI, expression levels tend to correlate with insulinsensitivity. Expression is increased 2-3 fold in the group ofpatients with high insulin sensitivity, compared to theinsulin-resistant group. This observation is consistent with theidea that triglyceride storage in adipocytes plays an importantrole in sequestering triglycerides and fatty acids away from thecirculation and peripheral tissues, thus enhancing insulinsensitivity in liver and muscle. This effect is not significant insubcutaneous adipose tissue (PubMed:18509062). In subcutaneousadipose tissue of diabetic patients, tends to negatively correlatewith body mass index and total fat mass, independently of insulinsensitivity (PubMed:18334488).
相似性
Contains 1 CIDE-N domain.
功能
May act as a CEBPB coactivator in white adipose tissueto control the expression of a subset of CEBPB downstream targetgenes, including SOCS1, SOCS3, TGFB1, TGFBR1, ID2 and XDH (Bysimilarity). Binds to lipid droplets and regulates theirenlargement, thereby restricting lipolysis and favoring storage. Atfocal contact sites between lipid droplets, promotes directionalnet neutral lipid transfer from the smaller to larger lipiddroplets. The transfer direction may be driven by the internalpressure difference between the contacting lipid droplet pair. Whenoverexpressed in preadipocytes, induces apoptosis or increases cellsusceptibility to apoptosis induced by serum deprivation or TGFBtreatment. As mature adipocytes, that express high CIDEC levels,are quite resistant to apoptotic stimuli, the physiologicalsignificance of its role in apoptosis is unclear.
同靶标产品
相关文献
提示: 发表研究结果有使用 bs-6796R 时请让我们知道,以便我们可以引用参考文章。作为回馈,资料提供者将获得我们送上的小礼品。
具体参考文献:bs-6796R 被引用于3文献中